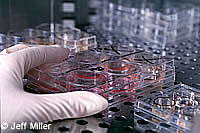

Il gruppo europeo sulle scienze biologiche esorta a proseguire nel sostegno alla ricerca sulle cellule staminali
Il gruppo europeo ad alto livello sulle scienze biologiche ha pubblicato una dichiarazione che esorta a proseguire nel sostegno alla ricerca sulle cellule staminali, purché opportunamente regolamentata. Il gruppo, costituito ad aprile del 2000 dal commissario della Ricerca Philippe Busquin per fornire pareri specializzati in materia di scienze e tecnologie biologiche, ha rilasciato la dichiarazione il 19 dicembre ad una conferenza intitolata "Le cellule staminali: terapie per il futuro?". Il gruppo ha dichiarato che "la ricerca attuale sulle cellule staminali, provenienti da tessuti differenziati o da embrioni, è valida dal punto di vista scientifico e promettente dal punto di vista medico, e dovrà essere sviluppata e sostenuta in modo attivo". Gli esperti hanno aggiunto che, "l'uso delle cellule staminali umane nella medicina rigenerativa, per quanto si trovi ancora in una fase di sviluppo iniziale, possiede il potenziale per realizzare progressi effettivi nella cura di diverse malattie gravi". Secondo il gruppo, la ricerca sulle cellule staminali umane potrebbe rivoluzionare la terapia in misura pari all'introduzione degli antibiotici. Il gruppo ha espresso il proprio accordo sui punti seguenti: - la clonazione riproduttiva deve essere proibita; - la derivazione di cellule staminali embrionali umane attraverso la clonazione terapeutica (ossia trapianti di nucleo) "non è stata mai conseguita e sembra incontrare difficoltà considerevoli". Il gruppo esorta a svolgere ulteriori ricerche sulle strategie per contribuire a superare il rigetto immunitario; - il gruppo ha acconsentito all'uso degli embrioni umani soprannumerari per la preparazione di linee di cellule staminali embrionali, evidenziando però il proprio rispetto per "il particolare status morale dell'embrione umano anche prima dell'impianto". La ricerca sulle cellule staminali provenienti da embrioni umani, ha affermato il gruppo, dovrà essere "opportunamente regolamentata, sottoposta alla valutazione tra pari, scientificamente fondata, orientata verso obiettivi fondamentali e conforme ai principi etici". - sia la ricerca finanziata dai fondi pubblici, sia quella finanziata dai fondi privati dovranno essere disciplinate dalle stesse normative; - un registro europeo delle linee cellulari staminali provenienti da embrioni umani dovrà essere istituito.